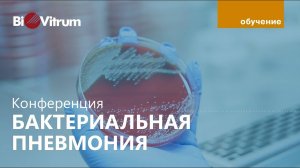
Диагностика бактериальной пневмонии

2:46:40
2:46:40
2024-08-09 10:13

 40:39
40:39

 40:39
40:39
2025-05-19 13:14

 2:36
2:36

 2:36
2:36
2025-06-10 11:07

 24:23
24:23

 24:23
24:23
2025-09-11 09:20

 23:31
23:31

 23:31
23:31
2025-09-28 11:00

 1:55:45
1:55:45

 1:55:45
1:55:45
2025-09-16 20:14

 10:29
10:29

 10:29
10:29
2025-09-22 09:39

 3:20
3:20

 3:20
3:20
2025-09-11 10:37

 4:18
4:18

 4:18
4:18
2025-09-21 11:49

 2:15
2:15

 2:15
2:15
2025-09-25 22:19

 5:52
5:52

 5:52
5:52
2025-09-25 23:50

 7:40
7:40

 7:40
7:40
2025-09-25 17:00

 16:17
16:17

 16:17
16:17
2025-09-17 18:32

 1:57:38
1:57:38

 1:57:38
1:57:38
2025-09-15 15:22

 34:56
34:56

 34:56
34:56
2025-09-12 16:44

 19:12
19:12

 19:12
19:12
2025-09-11 14:41

 1:50:16
1:50:16

 1:50:16
1:50:16
2025-09-15 14:19

 1:06:32
1:06:32
![Бунёд Бобокулов - Отам-онам (Премьера клипа 2025)]() 4:00
4:00
![Ольга Стельмах – Не будем всё усложнять (Премьера клипа 2025)]() 4:01
4:01
![NAIMAN - Плакала (Премьера клипа 2025)]() 2:21
2:21
![ARTIX - На небе луна (Премьера клипа 2025)]() 2:59
2:59
![Рейсан Магомедкеримов - Моя мадам (Премьера клипа 2025)]() 3:28
3:28
![ZIMMA - Город Тает (Премьера клипа 2025)]() 2:30
2:30
![SHAXO - Пьяница (Премьера клипа 2025)]() 3:32
3:32
![Шохжахон Раҳмиддинов - Арзон (Премьера клипа 2025)]() 3:40
3:40
![Инна Вальтер - Татарский взгляд (Премьера клипа 2025)]() 3:14
3:14
![Алмас Багратиони - Дети света (Премьера клипа 2025)]() 2:52
2:52
![Динара Швец - Нас не найти (Премьера клипа 2025)]() 3:46
3:46
![Zhamil Turan - Губки не целованы (Премьера клипа 2025)]() 2:37
2:37
![Шамиль Кашешов - Когда мы встретились с тобой (Премьера клипа 2025)]() 3:10
3:10
![Абрикоса, GOSHU - Удали из памяти (Премьера клипа 2025)]() 4:59
4:59
![Зульфия Чотчаева - Холодное сердце (Премьера клипа 2025)]() 2:52
2:52
![POLAT - Лунная (Премьера клипа 2025)]() 2:34
2:34
![Даша Эпова - Мой любимый человек (Премьера клипа 2025)]() 2:11
2:11
![Ахрор Гуломов - Ёмгирлар (Премьера клипа 2025)]() 3:49
3:49
![Бекзод Хаккиев - Нолалар (Премьера клипа 2025)]() 4:07
4:07
![АКУЛИЧ - Красные глаза (Премьера клипа 2025)]() 2:13
2:13
![Диспетчер | Relay (2025)]() 1:51:56
1:51:56
![Рок-н-рольщик | RocknRolla (2008) (Гоблин)]() 1:54:23
1:54:23
![Цельнометаллическая оболочка | Full Metal Jacket (1987) (Гоблин)]() 1:56:34
1:56:34
![Чёрный телефон 2 | Black Phone 2 (2025)]() 1:53:55
1:53:55
![Трон: Арес | Tron: Ares (2025)]() 1:52:27
1:52:27
![Большой куш / Спи#дили | Snatch (2000) (Гоблин)]() 1:42:50
1:42:50
![Хищник | Predator (1987) (Гоблин)]() 1:46:40
1:46:40
![Франкенштейн | Frankenstein (2025)]() 2:32:29
2:32:29
![Богомол | Samagwi (2025)]() 1:53:29
1:53:29
![Убойная суббота | Playdate (2025)]() 1:34:35
1:34:35
![Гедда | Hedda (2025)]() 1:48:23
1:48:23
![Девушка из каюты №10 | The Woman in Cabin 10 (2025)]() 1:35:11
1:35:11
![Только во сне | In Your Dreams (2025)]() 1:31:16
1:31:16
![Крысы: Ведьмачья история | The Rats: A Witcher Tale (2025)]() 1:23:01
1:23:01
![Орудия | Weapons (2025)]() 2:08:34
2:08:34
![Мужчина у меня в подвале | The Man in My Basement (2025)]() 1:54:48
1:54:48
![Баллада о маленьком игроке | Ballad of a Small Player (2025)]() 1:42:60
1:42:60
![Код 3 | Code 3 (2025)]() 1:39:56
1:39:56
![Кей-поп-охотницы на демонов | KPop Demon Hunters (2025)]() 1:39:41
1:39:41
![Французский любовник | French Lover (2025)]() 2:02:20
2:02:20
![Корги по имени Моко. Новый питомец]() 3:28
3:28
![Корги по имени Моко. Защитники планеты]() 4:33
4:33
![Пип и Альба. Приключения в Соленой Бухте! Сезон 1]() 11:02
11:02
![Игрушечный полицейский Сезон 1]() 7:19
7:19
![Лудлвилль]() 7:09
7:09
![Монсики]() 6:30
6:30
![Приключения Тайо]() 12:50
12:50
![Отряд А. Игрушки-спасатели]() 13:06
13:06
![Артур и дети круглого стола]() 11:22
11:22
![Енотки]() 7:04
7:04
![Супер Дино]() 12:41
12:41
![Роботы-пожарные]() 12:31
12:31
![Полли Покет Сезон 1]() 21:30
21:30
![Команда Дино. Исследователи Сезон 1]() 13:10
13:10
![Космический рейнджер Роджер Сезон 1]() 11:32
11:32
![Таинственные золотые города]() 23:04
23:04
![Карли – искательница приключений. Древнее королевство]() 13:00
13:00
![Умка]() 7:11
7:11
![Хвостатые песенки]() 7:00
7:00
![Псэмми. Пять детей и волшебство Сезон 1]() 12:17
12:17

 1:06:32
1:06:32Скачать Видео с Рутуба / RuTube
| 256x144 | ||
| 432x232 | ||
| 640x360 | ||
| 856x480 | ||
| 1280x720 |
 4:00
4:00
2025-11-21 13:29
 4:01
4:01
2025-11-21 13:05
 2:21
2:21
2025-11-18 12:25
 2:59
2:59
2025-11-18 12:12
 3:28
3:28
2025-11-20 13:54
 2:30
2:30
2025-11-21 13:20
 3:32
3:32
2025-11-18 12:49
 3:40
3:40
2025-11-21 13:31
 3:14
3:14
2025-11-18 11:36
 2:52
2:52
2025-11-20 13:43
 3:46
3:46
2025-11-12 12:20
 2:37
2:37
2025-11-13 11:00
 3:10
3:10
2025-11-22 12:41
 4:59
4:59
2025-11-15 12:21
 2:52
2:52
2025-11-18 11:48
 2:34
2:34
2025-11-21 13:26
 2:11
2:11
2025-11-15 12:28
 3:49
3:49
2025-11-15 12:54
 4:07
4:07
2025-11-11 17:31
 2:13
2:13
2025-11-15 12:35
0/0
 1:51:56
1:51:56
2025-09-24 11:35
 1:54:23
1:54:23
2025-09-23 22:53
 1:56:34
1:56:34
2025-09-23 22:53
 1:53:55
1:53:55
2025-11-05 19:47
 1:52:27
1:52:27
2025-11-06 18:12
 1:42:50
1:42:50
2025-09-23 22:53
 1:46:40
1:46:40
2025-10-07 09:27
 2:32:29
2:32:29
2025-11-17 11:22
 1:53:29
1:53:29
2025-10-01 12:06
 1:34:35
1:34:35
2025-11-19 10:39
 1:48:23
1:48:23
2025-11-05 19:47
 1:35:11
1:35:11
2025-10-13 12:06
 1:31:16
1:31:16
2025-11-21 20:18
 1:23:01
1:23:01
2025-11-05 19:47
 2:08:34
2:08:34
2025-09-24 22:05
 1:54:48
1:54:48
2025-10-01 15:17
 1:42:60
1:42:60
2025-10-31 10:53
 1:39:56
1:39:56
2025-10-02 20:46
 1:39:41
1:39:41
2025-10-29 16:30
 2:02:20
2:02:20
2025-10-01 12:06
0/0
 3:28
3:28
2025-01-09 17:01
 4:33
4:33
2024-12-17 16:56
2021-09-22 23:36
2021-09-22 21:03
 7:09
7:09
2023-07-06 19:20
 6:30
6:30
2022-03-29 19:16
 12:50
12:50
2024-12-17 13:25
 13:06
13:06
2024-11-28 16:30
 11:22
11:22
2023-05-11 14:51
 7:04
7:04
2022-03-29 18:22
 12:41
12:41
2024-11-28 12:54
2021-09-23 00:12
2021-09-22 23:09
2021-09-22 22:45
2021-09-22 21:49
 23:04
23:04
2025-01-09 17:26
 13:00
13:00
2024-11-28 16:19
 7:11
7:11
2025-01-13 11:05
 7:00
7:00
2025-06-01 11:15
2021-09-22 22:23
0/0

